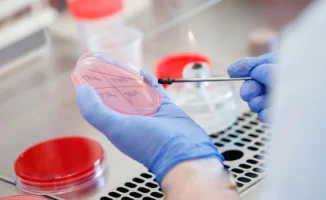

Зараженное мясо в Астане: что скрывают прилавки?

В Астане распространились опасения о том, что на рынках столицы, в частности на рынке "Әлем", может находиться мясо, зараженное сибирской язвой. В связи с этим Комитет ветеринарного контроля и надзора Министерства сельского хозяйства выступил с официальным комментарием.
Ситуация под контролем
Представители Комитета сообщили, что на сегодняшний день ни в Астане, ни на других рынках города не обнаружены случаи поступления или продажи зараженного мяса. Все поставки проходят обязательную ветеринарно-санитарную проверку, поэтому оснований для беспокойства нет.
Важной информацией является то, что в Атбасарском районе Акмолинской области, где ранее имели место единичные случаи заболевания среди животных, была завершена комплексная дезинфекция.
"Потенциально опасная продукция изъята и утилизирована в полном соответствии с санитарными нормами. Жители проходят медицинские осмотры", - отметили в Комитете.
Сибирская язва: факты
Сибирская язва является особо опасной инфекционной болезнью, затрагивающей как сельскохозяйственные, так и дикие животные, включая человека. Она может угрожать жизни даже при адекватном и своевременном лечении.
В завершение, Комитет ветеринарного контроля и надзора призвал граждан доверять только официальным источникам информации и напомнил о юридической ответственности за распространение ложных данных.
Напомним, что недавно несколько человек заразились сибирской язвой в Атбасарском районе, что также прокомментировала министр здравоохранения Акмарал Альназарова.